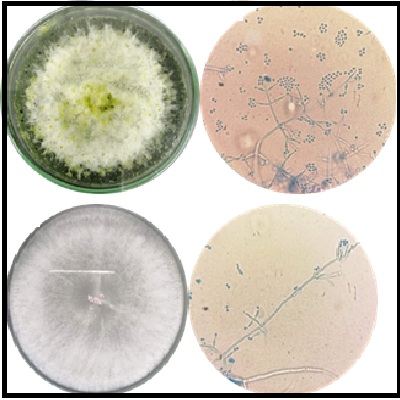

In vitro antagonistic activity of native Trichoderma strains against Botrytis sp
Actividad antagónica in vitro de cepas nativas de Trichoderma contra Botrytis sp
DOI:
https://doi.org/10.24054/bistua.v23i1.3660Keywords:
Biological control; phytopathogen; agrochemicals, grey mould.Abstract
Botrytis cinerea is a plant pathogen that affects a wide range of plants and is responsible for severe economic losses in more than 200 crops worldwide. Although the use of fungicides is the most common strategy for its control, the genetic plasticity of this fungus allows it to develop resistance. Consequently, biological control has gained ground as an alternative or complementary approach to fungicides. In this respect, the genus Trichoderma is the most extensively studied group with the greatest potential for biological control of B. cinerea. Therefore, the search and study of native Trichoderma strains with biocontrol potential is a line of interest for the local and regional agricultural sector. This study reports the in vitro investigation of the biocontrol capacity of a commercial product, in comparison with the antagonistic power of two native strains isolated from soils in the agricultural areas of the municipalities of Pamplona (TN01) and Bucarasica (TN02), in Norte de Santander. Morphological characterisation determined that both strains are taxonomically located in the Viride clade of the genus Trichoderma. The growth rate and the percentage of radial growth inhibition (PICR) of the antagonists were determined using the dual culture technique. The results indicated that TN01 was the strain with the highest potential to be used as a biological controller of Botrytis spp. This strain showed the highest apical growth rate and achieved a PICR of 80% at the end of the experiment, exceeding that achieved by the commercial reference product. Conversely, strain TN02 exhibited a diminished antagonistic capacity, with a PICR of 55% after a 12-day period. This observation suggests the potential for the autochthonous strain TN01 to be evaluated under cultivation conditions.
Downloads
References
Aldana Bohórquez, S.M. and García Rico, R.O. 2019. Efecto de diferentes condiciones de estrés sobre el crecimiento vegetativo del hongo filamentoso Acremonium chrysogenum. BISTUA REVISTA DE LA FACULTAD DE CIENCIAS BASICAS. 17, 2 (Aug. 2019), 182–195. https://doi.org/10.24054/bistua.v17i2.248
Azevedo, D.M.Q., Martins, S.D.S., Guterres, D.C., Martins, M.D., Araújo, L., Guimarães, L.M.S., Alfenas, A.C., Furtado, G.Q., 2020. Diversity, prevalence and phylogenetic positioning of Botrytis species in Brazil. Fungal Biol. 124, 940–957. https://doi.org/10.1016/j.funbio.2020.08.002
Brankica, T., Delibasic, G., Milivojevic, J., Nikolic, M., 2009. Characterization of Botrytis cinerea isolates from small fruits and grapevine in Serbia. Arch. Biol. Sci. 61. https://doi.org/10.2298/ABS0903419T
Cheung, N., Tian, L., Liu, X., Li, X., 2020. The Destructive Fungal Pathogen Botrytis cinerea-Insights from Genes Studied with Mutant Analysis. Pathog. Basel Switz. 9, E923. https://doi.org/10.3390/pathogens9110923
Crous, P.W., Verkley, G.J.M., Groenewald, J.Z., Samson, R.A., 2009. Fungal Biodiversity. CBS Laboratory Manual Series. Westerdijk Fungal Biodiversity Institute
Cruz, A.F., Barka, G.D., Sylla, J., Reineke, A., 2018. Biocontrol of strawberry fruit infected by Botrytis cinerea: Effects on the microbial communities on fruit assessed by next-generation sequencing. J. Phytopathol. 166, 403–411. https://doi.org/10.1111/jph.12700
Debnath, S., Chakraborty, G., Dutta, S.S., Chaudhury, S.R., Das, P., Saha, A.K., 2020. Potential of Trichoderma species as biofertilizer and biological control on Oryza sativa L. cultivation. Biotecnol. Veg. 20, 1–16.
Díaz de la Osa A, Almenares Casanova M, Fernández Millares B, Aguado Casas ME, Rojas L, Zeilinger S, Hernández-Rodríguez A. Secondary metabolites and extracellular proteases contribute to the antagonistic action of indigenous Trichoderma strains against Botrytis cinerea. Fungal Biol. 2025 Feb;129(1):101530. doi: 10.1016/j.funbio.2024.101530. Epub 2024 Dec 31. PMID: 39826978.
Elías, R., Arcos, O., Arbeláez, G., 1993. Estudio del antagonismo de algunas especies de Trichoderma aisladas de suelos colombianos en el control de Fusarium oxysporum y Rhizoctonia solani. Agron. Colomb. 10, 52–61.
Fernandes, V.C., Maia, M.L., Correia Sá, L., Sousa, S., Paíga, P., Vera, J.L., Domingues, V.F., Delerue-Matos, C., 2021. Extraction Procedures and Chromatography of Pesticides Residues in Strawberries, in: Inamuddin, Ahamed, M.I., Lichtfouse, E. (Eds.), Sustainable Agriculture Reviews 47: Pesticide Occurrence, Analysis and Remediation Vol. 1 Biological Systems, Sustainable Agriculture Reviews. Springer International Publishing, Cham, pp. 167–201. https://doi.org/10.1007/978-3-030-54712-7_5
Fernández, O, D., Grabke, A., Li, X., Schnabel, G., 2015. Independent Emergence of Resistance to Seven Chemical Classes of Fungicides in Botrytis cinerea. Phytopathology® 105, 424–432. https://doi.org/10.1094/PHYTO-06-14-0161-R
Fernández, O, D., Li, X.P., Wang, F., Schnabel, G., 2012. First Report of Gray Mold of Strawberry Caused by Botrytis caroliniana in North Carolina. Plant Dis. 96, 914–914. https://doi.org/10.1094/PDIS-12-11-1018-PDN
García-Rico, R.O. and Fierro, F., 2017. Papel de las subunidades alfa de proteínas G en los procesos morfogénicos de hongos filamentosos de la división Ascomycota. Rev. Iberoam. Micol. 34, 1–9. https://doi.org/10.1016/j.riam.2016.06.005
Harman, G.E., Kubicek, C.P., 2002. Trichoderma And Gliocladium. Volume 1: Basic Biology, Taxonomy and Genetics. CRC Press.
He, L., Cui, K., Li, T., Song, Y., Liu, N., Mu, W., Liu, F., 2020. Evolution of the Resistance of Botrytis cinerea to Carbendazim and the Current Efficacy of Carbendazim Against Gray Mold After Long-Term Discontinuation. Plant Dis. 104, 1647–1653. https://doi.org/10.1094/PDIS-11-19-2457-RE
Isaza, L., Zuluaga, Y.P., Marulanda, M.L., 2019. Morphological, pathogenic and genetic diversity of Botrytis cinerea Pers. in blackberry cultivations in Colombia. Rev. Bras. Frutic. 41. https://doi.org/10.1590/0100-29452019490
Jaklitsch, W.M., 2009. European species of Hypocrea Part I. The green-spored species. Stud. Mycol., European species of Part I. The green-spored species 63, 1–91. https://doi.org/10.3114/sim.2009.63.01
Jaklitsch, W.M., Voglmayr, H., 2015. Biodiversity of Trichoderma (Hypocreaceae) in Southern Europe and Macaronesia. Stud. Mycol., Hypocrealean lineages of industrial and phytopathological importance 80, 1–87. https://doi.org/10.1016/j.simyco.2014.11.001
Kumar, Manish, Ashraf, S., 2017. Role of Trichoderma spp. as a Biocontrol Agent of Fungal Plant Pathogens, in: Kumar, V., Kumar, Manoj, Sharma, S., Prasad, R. (Eds.), Probiotics and Plant Health. Springer, Singapore, pp. 497–506. https://doi.org/10.1007/978-981-10-3473-2_23
Martinez Y, Ribera J, Schwarze FWMR, De France K. Biotechnological development of Trichoderma-based formulations for biological control. Appl Microbiol Biotechnol. 2023 Sep;107(18):5595-5612. doi: 10.1007/s00253-023-12687-x. Epub 2023 Jul 21. PMID: 37477696; PMCID: PMC10439859.
McGuire, A.V., Northfield, T.D., 2021. Identification and evaluation of endemic Metarhizium strains for biological control of banana rust thrips. Biol. Control 162, 104712. https://doi.org/10.1016/j.biocontrol.2021.104712
Meng, L., Mestdagh, H., Ameye, M., Audenaert, K., Höfte, M., Van Labeke, M.-C., 2020. Phenotypic Variation of Botrytis cinerea Isolates Is Influenced by Spectral Light Quality. Front. Plant Sci. 0. https://doi.org/10.3389/fpls.2020.01233
Mirzaei, S., Goltapeh, E.M., Shams-Bakhsh, M., Safaie, N., 2008. Identification of Botrytis spp. on Plants Grown in Iran. J. Phytopathol. 156, 21–28. https://doi.org/10.1111/j.1439-0434.2007.01317.x
Pei, Y., Tao, Q., Zheng, X., Li, Y., Sun, X., Li, Z., Qi, X., Xu, J., Zhang, M., Chen, H., Chang, X., Tang, H., Sui, L., Gong, G., 2019. Phenotypic and Genetic Characterization of Botrytis cinerea Population from Kiwifruit in Sichuan Province, China. Plant Dis. 103, 748–758. https://doi.org/10.1094/PDIS-04-18-0707-RE
Petrasch, S., Knapp, S.J., Kan, J.A.L. van, Blanco-Ulate, B., 2019. Grey mould of strawberry, a devastating disease caused by the ubiquitous necrotrophic fungal pathogen Botrytis cinerea. Mol. Plant Pathol. 20, 877–892. https://doi.org/10.1111/mpp.12794
Qin, W.-T., Zhuang, W.-Y., 2016. Seven wood-inhabiting new species of the genus Trichoderma (Fungi, Ascomycota) in Viride clade. Sci. Rep. 6, 27074. https://doi.org/10.1038/srep27074
Samaniego-Fernández, L.M., Harouna, M., Corbea, O., Rondón-Castillo, A.J., Placeres-Espinosa, I., Samaniego-Fernández, L.M., Harouna, M., Corbea, O., Rondón-Castillo, A.J., Placeres-Espinosa, I., 2018. Aislamiento, identificación y evaluación de cepas autóctonas de Trichoderma spp. antagonistas de patógenos del suelo. Rev. Protección Veg. 33.
Samuels, G.J., Dodd, S.L., Lu, B.-S., Petrini, O., Schroers, H.-J., Druzhinina, I.S., 2006. The Trichoderma koningii aggregate species. Stud. Mycol. 56, 67–133. https://doi.org/10.3114/sim.2006.56.03
Shah, M.M., Afiya, H., 2019. Introductory Chapter: Identification and Isolation of Trichoderma spp. - Their Significance in Agriculture, Human Health, Industrial and Environmental Application, Trichoderma - The Most Widely Used Fungicide. IntechOpen. https://doi.org/10.5772/intechopen.83528
Torrent C, Gil-Durán C, Rojas-Aedo JF, Medina E, Vaca I, Castro P, García-Rico RO, Cotoras M, Mendoza L, Levicán G, Chávez R. Role of sfk1 Gene in the Filamentous Fungus Penicillium roqueforti. Front Microbiol. 2017 Dec 6;8:2424. doi: 10.3389/fmicb.2017.02424. PMID: 29270163; PMCID: PMC5723657.
Woo SL, Hermosa R, Lorito M, Monte E. Trichoderma: a multipurpose, plant-beneficial microorganism for eco-sustainable agriculture. Nat Rev Microbiol. 2023 May;21(5):312-326. doi: 10.1038/s41579-022-00819-5. Epub 2022 Nov 22. PMID: 36414835.
Zin, N.A., Badaluddin, N.A., 2020. Biological functions of Trichoderma spp. for agriculture applications. Ann. Agric. Sci. 65, 168–178. https://doi.org/10.1016/j.aoas.2020.09.003
Additional Files
Published
Issue
Section
License
Copyright (c) 2025 © Autores; Licencia Universidad de Pamplona

This work is licensed under a Creative Commons Attribution-NonCommercial-NoDerivatives 4.0 International License.
© Autores; Licencia Universidad de Pamplona





